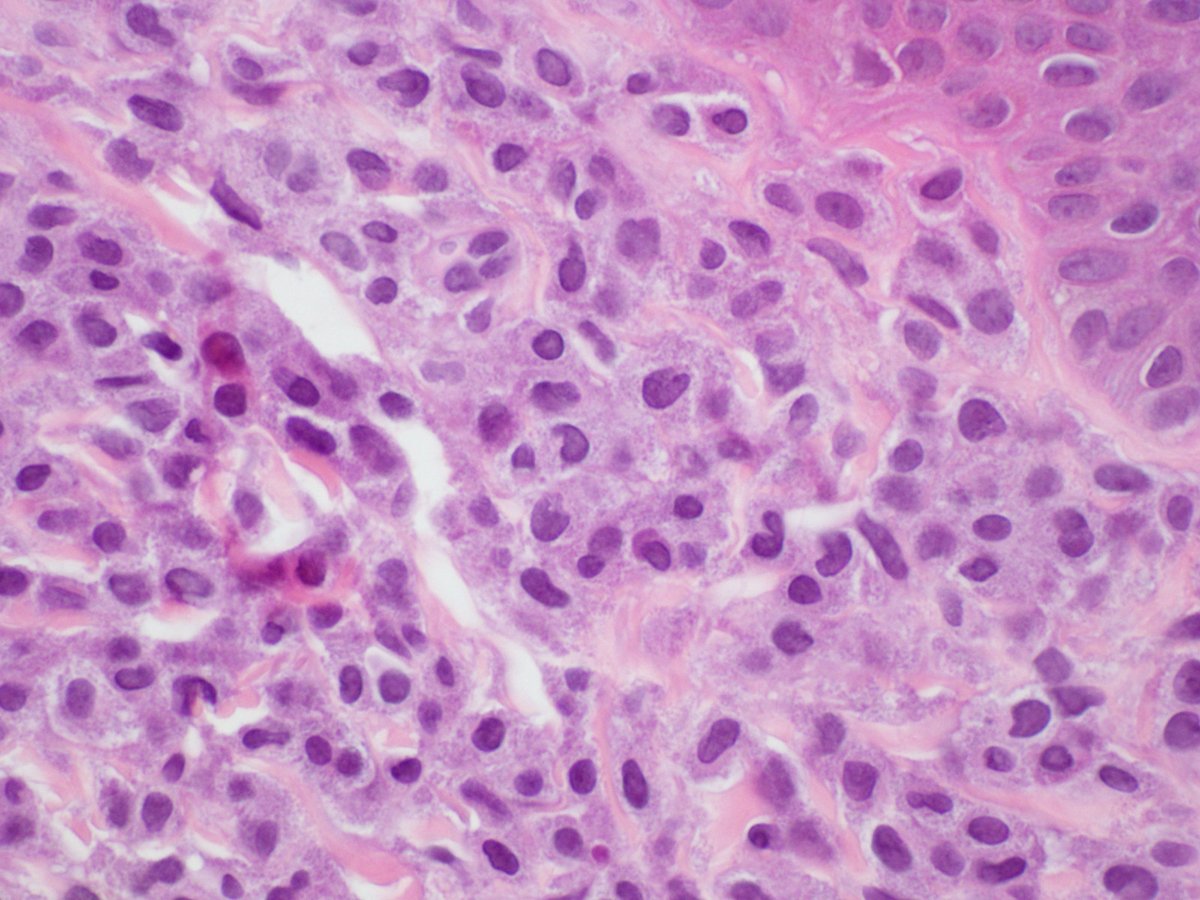
Interesting case (from our archives!) to start the week: A woman in her 60s with asthma and chronic rhinitis presents with a new morbilliform rash on trunk & extremities. Skin biopsy shown below; initial thoughts/next steps to consider? More information to follow...  #PathTwitter

Interesting case (from our archives!) to start the week: A woman in her 60s with asthma and chronic rhinitis presents with a new morbilliform rash on trunk & extremities. Skin biopsy shown below; initial thoughts/next steps to consider? More information to follow... #PathTwitter
Looks like everyone is on the right track with a mast cell process...which of the following would be most helpful in further classifying this patient's diagnosis?
Correct! As good #pathologists we will of course request more tissue to examine, and the patient needs a bone marrow biopsy to evaluate extent of disease (i.e. cutaneous vs systemic). Images from this patient's aspirate and biopsy are shown below (1/4):
Serum tryptase is a good option and may support the diagnosis. Biopsy is a better choice, as per WHO, finding dense mast cell aggregates in BM or other organs is a major diagnostic criterion, while serum tryptase is a minor criterion. See https://www.ncbi.nlm.nih.gov/pmc/articles/PMC5356454/ (2/4):
Similarly, the presence of bone lesions would be important clinical info that could impact sub-classification of the disease process, as well as guide therapy. However, full body (or even targeted) imaging is not necessarily indicated at this point for this patient (3/4).
Additional info: Normal CBC/CMP, elevated LFTs, serum tryptase=176 μg/L, BM reported as 27% mast cells with otherwise normal hematopoiesis, and palpable splenomegaly. Given all of these findings, what is the best diagnosis? Final answer to follow tomorrow!
This was signed out as mast cell leukemia (MCL), as the mast cells comprised >20% of the BM cellularity. Aggressive SM (ASM) is a consideration given splenomegaly, but meeting MCL criteria rules out ASM per WHO 2016 guidelines. #hemepath #dermpath #WHO #MUSC #pathology

 Read on Twitter
Read on Twitter